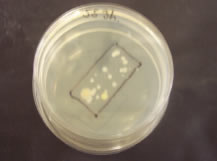
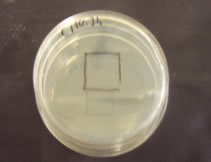

|
|
iionisation, kupfer, silber, krankenhaus, klinik, hotel,
klima anlage, kühlturm, pool, schwimmbad, spa, legionelle,
legionela,
desinfektion, wasser, chlor, chlororganica, chemiefrei, elektrode,
bakterien,
algen, pH, wasserfilter, elektrolyse, Streptococus faecalis, virus,
protozoa,
who, EU, trinkwasserverordnung, ökologisch, wasserbehandlung,
waschanlagen,
industriewasser |
| From:
http://www.copper.org/education/Kids/fingerprint_disinfection_test.html |
|
|
|
|
|
|
| Stainless Steel S304 with Extensive Growth | Copper C110 showing no growth |
Copyright 2007 by ClearWater Tec S.L. |
|